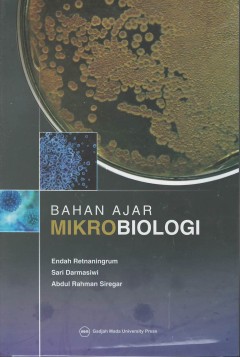

Ditapis dengan
Pengambilan Keputusan: Konsep, Proses, Metode, Komunikasi dan Negosiasi Konfl…
- Edisi
- Cetakan 1
- ISBN/ISSN
- 978-623-02-4254-0
- Deskripsi Fisik
- x, 212 hal: ilustrasi ; 23 cm
- Judul Seri
- -
- No. Panggil
- 658.403 DIL p
- Edisi
- Cetakan 1
- ISBN/ISSN
- 978-623-02-4254-0
- Deskripsi Fisik
- x, 212 hal: ilustrasi ; 23 cm
- Judul Seri
- -
- No. Panggil
- 658.403 DIL p
Perilaku organisasi: di era revolusi industri 4.0
- Edisi
- 1 Cet 1
- ISBN/ISSN
- 978-623-231-440-5
- Deskripsi Fisik
- xviii, 247 hlm.; 23 cm
- Judul Seri
- -
- No. Panggil
- 302.35 WAH p
- Edisi
- 1 Cet 1
- ISBN/ISSN
- 978-623-231-440-5
- Deskripsi Fisik
- xviii, 247 hlm.; 23 cm
- Judul Seri
- -
- No. Panggil
- 302.35 WAH p
Psikologi suatu pengantar : dalam perspekif Islam
Kolaborasi teori psikologi modern dengan konsep Islam tentang manusia sangat jarang digarap dengan serius. Perspektif Islam tentang manusia masih tersebar sebagai teks suci, belum terumuskan dalam bentuk teori empiris. Padahal bukan tidak mungkin kolaborasi tersebut dapat melahirkan teori psikologi baru yang sangat mungkin memberikan kontribusi bagi usaha memahami sisi psikologi manusia. Dimot…
- Edisi
- -
- ISBN/ISSN
- 978-623-218-973-7
- Deskripsi Fisik
- xii, 214 hal; 21cm
- Judul Seri
- -
- No. Panggil
- 297.261 SHA p
Bahan ajar mikrobiologi
- Edisi
- -
- ISBN/ISSN
- 978-602-386-175-0
- Deskripsi Fisik
- xvi, 152 hal.: ill.; 23 cm
- Judul Seri
- -
- No. Panggil
- 616.01 RET b
- Edisi
- -
- ISBN/ISSN
- 978-602-386-175-0
- Deskripsi Fisik
- xvi, 152 hal.: ill.; 23 cm
- Judul Seri
- -
- No. Panggil
- 616.01 RET b
 Karya Umum
Karya Umum  Filsafat
Filsafat  Agama
Agama  Ilmu-ilmu Sosial
Ilmu-ilmu Sosial  Bahasa
Bahasa  Ilmu-ilmu Murni
Ilmu-ilmu Murni  Ilmu-ilmu Terapan
Ilmu-ilmu Terapan  Kesenian, Hiburan, dan Olahraga
Kesenian, Hiburan, dan Olahraga  Kesusastraan
Kesusastraan  Geografi dan Sejarah
Geografi dan Sejarah